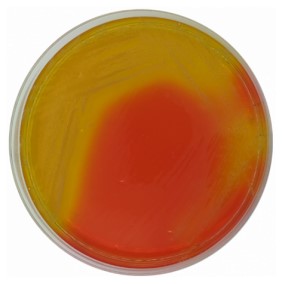
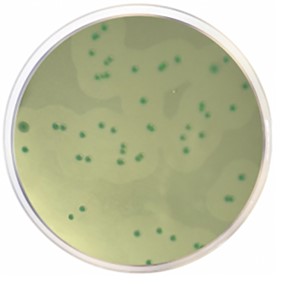
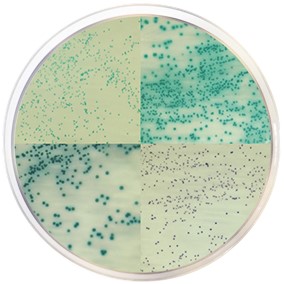
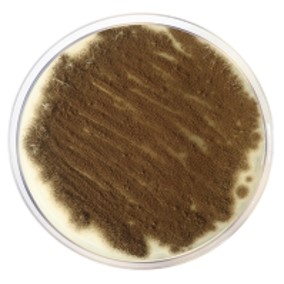

+56 9 34360138
ventas@jm-lab.cl
De la mas alta Calidad..
BURKHOLDERIA CEPACIA
Si andas Buscando poder determinar el patógeno emergente BURKHOLDERIA CEPACIA, contáctanos. +56 9 58833220
Sobre nosotros
En JM LAB, Somos una empresa dedicada a entregar soluciones integrales para su laboratorios de Microbiologia.
Contamos con una amplia gama en Medios de cultivos, insumos descartables, equipamiento para laboratorios, ademas entregamos toda la asesoría necesaria para la implementacion de laboratorios y técnicas analíticas de acuerdo a sus necesidades, con respuestas rápidas y oportunas.
Visión
Ser una empresa lider en el mercado de soluciones integrales para Microbiologia y ser reconocidos por nuestro compromiso de alta calidad, entrega de servicio postventa de excelencia y gran capacidad tecnica-profesional. Para lo cual trabajamos permanentemente para ser una empresa ágil, eficiente, flexible y constantemente efectuando mejoras continuas en nuestros procesos.

En JM LAB contamos con un equipo de profesionales con mas de 23 años de experiencia Tecnica y comercial.
Nuestro equipo altamente calificado siempre se encuentran listos para ayudarlo en sus requerimientos y nuevos desafios..
Brindamos asesoría y productos de la mas alta calidad en el mercado.
Contacto
ventas@jm-lab.cl
Teléfono:
+ 56 934360138
Teléfono:
+ 56 958833220
Horario de atención
Hours:
9:00 hrs. - 18:00 hrs.
Nuestros Lineas de Productos
Contamos con Medios de cultivos deshidratados, los cuales poseen una gran variedad de aplicaciones tanto en microbiologia industrial(alimentaria, cosmetica, farmaceuticas, veterinarias, producción de vacunas, laboratorios de servicios entre otros)como en laboratorios de microbiología clínica. Los medios deshidratados poseen una mayor vida util hasta 5 años, permitiendo prepararlos de manera comoda, fácil y económica.
Nuestra marca representada es CONDALAB. Empresa española con mas de 60 años en el mercado. http://www.condalab.com

Contamos con medios de cultivos cromogénico los cuales son medios microbiologicos adecuados para la incubación, diferenciación o seleccion de diversos microorganismos tanto patógenos como indicadores.
Los medios Cromogenicos, contienen un sustrato cromogénico incoloro, que gracias a las actividades enzimáticas específicas de cada microorganismo, es degradado liberando una parte de este, llamada cromóforo, otorgando a la colonia un color intenso y específico que permite una identificación de la bacteria a simple vista. Por lo tanto es muy fácil y precisa la diferenciación.
Poseemos un amplio portafolio de medios cromogenicos entre los cuales están: Listeria spp, L. Monocytogenes, Salmonella spp, e.Coli/Coliformes, E.coli o157:H7, Bacillus Cereus S. Aureus, Speudomonas, Enterobacter Sakazakii, entre otros.
Nuestra marca representada es CONDALAB. Empresa española con mas de 60 años en el mercado.http://www.condalab.com
Contamos con los siguientes medios:
Caldo Soja Tripticaseína (TSB): Para uso general en laboratorio y cultivo de microorganismos exigentes.
Agua peptonada Tamponada: diluyente para la homogenización de muestras en el análisis microbiológico de los alimentos.
CALDO 1/2 FRASER: Medio de eriquecimiento para la detección y aislación de Listeria en mustras de alimentos y ambientales.
Contamos con agarosas para Industria: Biología molecular / PCR y Electroforesis / Clonaje entre otro usos.
Agarosas: D5; D1 LOW EEO; D1 HIGHT EEO; D1 MEDIUM EEO; D2; E; LM SIEVE; NOVAGEL GQT; FP DNA, entre otras.

Contamos con un amplio portafolio de material descartables y productos para su laboratorio entre los cuales se encuentran:Placas Petri, Asas de Inoculación, pipetas serológicas, puntas, Asas de drigalsky (rastrillos), bolsas, Crisoles entre otros.

Contamos con equipamiento para su laboratorio entre los cuales se encuentran:
Equipamiento tradicional y equipamiento para la automatización del laboratorio desde preparación de la muestra hasta interpretación de Resultados.
Las tinciones y colorantes se utilizan principalmente en procedimientos de identificación de los microorganismos basados en las características histológicas o morfológicas de las bacterias. Contamos con productos que se ajusten a sus necesidades desde la tradicional tinción de Gram para clasificar microorganismos hasta técnicas más especializadas para la determinación de contaminaciones por micobacterias en muestras clínicas.


CRYOINSTANT MIXED
CRIOPERLAS PARA LA PRESERVACION DE CEPAS DE MICROORGANISMO.
Es un excelente medio de conservación para sus cepas. Minimiza el riesgo de contaminación cruzada. Ahorra tiempo y espacio. No tiene que descongelar todo el vial para extraer una crioperla. Cada perla equivale a un cultivo.
Encuentre la asesoría requerida para su laboratorio
Novedades
El complejo Burkholderia cepacia (Bcc), es un grupo de 17 especies de bacterias estrechamente relacionadas. Bcc son bacterias aerobias Gram-negativas que se pueden encontrar en el agua y suelo.
El agua es la materia prima más utilizada en las formulaciones farmacéuticas, por lo que el Bcc puede contaminar estas preparaciones. La USP recomienda este medio para asegurar la ausencia de Bcc en productos regulados. Los Bcc son patógenos oportunistas y pueden plantear graves problemas médicos. riesgos para las poblaciones susceptibles a infecciones, como las personas mayores y los niños, así como para las poblaciones inmunodeprimidas como las que padecen fibrosis quística, cáncer y VIH.
En JM LAB, contamos con agar y suplementos para deteccion de este complejo de bacterias.
Contáctanos al Correo :
En Seguridad Alimentaria podemos encontrar un gran número de indicadores, sin embargo, hay un par que brillan por su continua presencia, siendo uno de ellos Listeria.
Listeria spp. es un grupo De bacilos Gram positivos y anualmente representa una gran parte de las alertas sanitarias y retiradas de alimentos a nivel mundial. Y es que a pesar que sólo 2 de las 17 especies de este género son patógenas para el ser humano, una de ellas es la causante de la Listeriosis.
Listeria monocytogenes es la responsable de esta enfermedad, que tiene una baja incidencia en comparación con otras infecciones transmitidas por alimentos, pero simultáneamente presenta la tasa de mortalidad más alta, entre el 15 – 30 %,
En JM LAB contamos con CondaChrome Listeria®, un medio cromogénico. este medio de cultivo, las especies de Listeria crecerán de un tono azul-verdoso, debido a que la composición del mismo incluye al X-glucósido, que es el sustrato para la detección de la enzima β-glucosidasa.
Contáctanos al Correo :
BOLETÍN INFORMATIVO
Staphylococcus aureus
oportunista silencioso
S. aureus es un gram positivo responsable de la mayoría de las infecciones cutáneas ocasionadas por bacterias, incluyendo tanto infecciones superficiales (impétigo y abrasiones infectadas) como invasivas (abscesos subcutáneos y úlceras infectadas). Y es que, aunque la epidermis y la dermis contribuyen a la defensa, este patógeno utiliza diversos mecanismos y factores de virulencia para evadir dichas defensas y así facilitar la colonización y promover la infección de la piel y mucosas.
¿Cómo puedo detectar fácilmente S. aureus en los cosméticos?
CondaChrome® Staphylococcus spp.
Tiene en su formulación, además de los nutrientes necesarios para el crecimiento de estafilococos, una mezcla de sustratos cromogénicos para realizar la identificación y diferenciación simultánea de las principales especies de este género bacteriano como S. aureus, S. epidermis, S. xylosus y S. saprophyticus.
Los cromóforos:
Aportan el color con lo cual las distintas especies se identifican fácilmente al presentar un color característico.
Patógenos alimentarios
Formadores de Biofilms
Una de las principales preocupaciones hoy en día en seguridad alimentaria está representada por la presencia de microorganismos patógenos. Dicha presencia puede venir determinada por unos protocolos deficientes de limpieza en superficies y del material en contacto con los alimentos.
La deficiencia de dichos protocolos se ve acusada por la existencia de estructuras microbianas como los biofilms, y suelen ser la causa fundamental de contaminación del producto final. Su formación sobre productos o en el entorno (superficies, utensilios, equipos…) aumentan considerablemente la probabilidad de contaminación cruzada y de contaminaciones durante el procesado.
No solo los productos son susceptibles de ser dañados y contaminados, sino que también los equipos e instalaciones pueden sufrir alteraciones que repercuten en su rendimiento y vida útil. En sistemas de agua potable, por ejemplo, se pueden obstruir cañerías, disminuyendo el flujo e incrementando el coste energético. En industrias lácteas o productoras de zumos, se pueden dañar los filtros y membranas por la adsorción de microorganismos, disminuyendo el rendimiento de los procesos y siendo focos de contaminación al estar en contacto con el producto.
La mayoría de las especies bacterianas tienen la capacidad de formar biofilms, A continuación, enumeraremos algunas de ellas:
Listeria monocytogenes;Salmonella spp:Escherichia coli Pseudomonas spp;Campylobacter jejuni.

INSUMOS
PUNTAS
CON Y SIN FILTRO

PLACAS DESECHABLES
Consulta por toda nuestra Linea de insumos descartables
ASAS DE
INOCULACIÓN

RASTRILLOS DE SIEMBRA

Ejemplos
EQUIPAMIENTO
Dilutores automáticos

Homogenizadores

Sencilla y segura de las bacterias de muestras sólidas.
Es representativa de la contaminación global de la muestra.
Bombas Peristálticas

¿Tiene alguna pregunta?
¿ Para que se utilizan las Perlas de Conservación (Cryopreserve)?
Las perlas de conservacion son un metodo sencillo y seguro para la preservación de microorganismos a largo plazo.
Se puedan usar en cualquier laboratorio microbiológico independientemente de tu sector:

Ventajas
Sin limitaciones para bacterias, hongos, levaduras y organismos complejos
Preserva las características originales de las cepas
Ahorro de tiempo y espacio: 25 subcultivos por criotubo
Sencillo sistema de clasificación: disponible en 5 colores
Más eficiente respecto a otros métodos de conservación
¿Con que medio de cultivo puedo identificar Hongos y Levaduras ?
Para la identificación, cultivo y enumeración de hongos y levaduras puedes utilizar Agar Dextrosa y Patata.
El Agar Dextrosa y Patata está recomendado por APHA y FDA para cultivar levaduras y mohos. También se puede usar en la identificación de hongos y levaduras en paralelo con su morfología celular, o en métodos de microcultivo en portaobjetos.
¿NECESITAS ANALIZAR UN GRAN
NÚMERO DE MUESTRAS A DIARIO?
Contamos con Bolsas de medios de cultivos, preparadas
" listas para ser usadas"

Caldo 1/2 half Fraser ISO
Enriquecimiento primario para Listeria spp
proporciona mayores m índices de recuperación del microorganismo a partir de alimentos. Formato de 2x5 lt. autonomia para 44 muestras de 225 ml c/u.

Agua peptonada tamponada ISO
Diluyente general en Alimentación.

Caldo TSB (Trypticasein Soy Broth) EP/USP/ISO
Para uso general en laboratorio y cultivo de microorganismos exigentes.

Como puedo determinar E.coli y otros coliformes de manera simultánea?
Con medio cromogenico de nuestra marca representada E.coli coliforms Chromogenic Agar .
De muy fácil interpretación, resultados en 24 hrs.

¿Que ocurre si no trato correctamente mi muestra cosmética?
En la industria cosmética, cómo en cualquier análisis de control de calidad de producto final, ha de utilizarse un caldo para diluir o enriquecer la muestra que vamos a analizar. La presencia de los conservantes en cosmética hace que este primer paso del procedimiento sea vital, ya que, si utilizásemos un diluyente habitual, podríamos obtener falsos negativos.

Contamos con un amplio portafolio de medios de cultivo asi como agares selectivos para la deteccion en patógenos de productos cosméticos.
contactenos si requiere mayor información.
ASESORÍA INTEGRAL PARA SU LABORATORIO

JM LAB LTDA.
EXPERIENCIA A SU SERVICIO.
SOLUCIONES INTEGRALES PARA SU LABORATORIO Contamos con un equipo de profesionales con mas de 23 años de experiencia, que atenderan sus requerimientos.
Contáctenos
Teléfono +56 9 34360138
ventas@jm-lab.cl